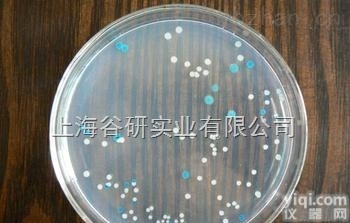
<em>明胶</em>培养基（营养<em>明胶</em>培养基）<em>实验</em>方法

明胶酶谱实验
- 型号:明胶酶谱MMP活性检测实验外包服务
- 供应商:北京嘉美臻元生物技术有限公司
- 供应商报价:¥480
- 标签:明胶酶谱实验、明胶酶谱实验价格、明胶酶谱实验厂家、、、北京嘉美臻元生物技术有限公司
| 按总体积 | 2.5ml |
| ddH2O: | 1.575ml |
| 30%C3H5NO溶液: | 0.42ml |
| 1.0mol/L Tris (PH=6.8): | 0.315ml |
| 10%SDS: | 25ul |
| 20Xsubstrate: | 125ul |
| 10%(NH4)2S2O8: | 25ul |
| TEMED: | 3ul |
| 按总体积 | 10ml |
| ddH2O: | 4.1ml |
| 30%C3H5NO溶液: | 2.7ml |
| 1.0mol/L Tris (PH=8.8): | 2.5ml |
| 10%SDS: | 100ul |
| 20Xsubstrate: | 500ul |
| 10%(NH4)2S2O8: | 100ul |
| TEMED: | 6ul |

Lanes: | Lane1 | Lane2 | Lane3 | Lane4 | Lane5 | Lane6 | Lane7 | Lane8 | Lane9 | LaneP |
Rows | (IOD) | (IOD) | (IOD) | (IOD) | (IOD) | (IOD) | (IOD) | (IOD) | (IOD) | (IOD) |
MMP-9 | 16200 | 20200 | 26700 | 33200 | 30474 | 43300 | 38600 | 35131 | 23500 | 60323 |
MMP-2 | 12535 | 101884 | 12974 | 12322.6 | 12170.2 | 11685 | 12481 | 9677.5 | 12522 | 16578 |
样本 | 1 | 2 | 3 | 4 | 5 | 6 | 7 | 8 | 9 | P |

Lanes: | Lane 1 | Lane 2 | Lane 3 | Lane 4 | Lane 5 | Lane 6 | Lane 7 | Lane 8 | Lane 9 | Lane P |
Rows | (IOD) | (IOD) | (IOD) | (IOD) | (IOD) | (IOD) | (IOD) | (IOD) | (IOD) | (IOD) |
MMP-9 | 25390 | 25500 | 44900 | 42000 | 60300 | 43400 | 43100 | 36600 | 33400 | 67703 |
MMP-2 | 10120 | 12053 | 13797 | 15995 | 15138 | 13139 | 15800 | 12447 | 12514 | 14632 |
样本 | 10 | 11 | 12 | 13 | 14 | 15 | 16 | 17 | 18 | P |

Lanes: | Lane 1 | Lane 2 | Lane P |
Rows | (IOD) | (IOD) | (IOD) |
MMP-9 | 29000 | 66424 | 66935 |
MMP-2 | 3164.7 | 9350.6 | 13975 |
样本 | 19 | 20 | P |